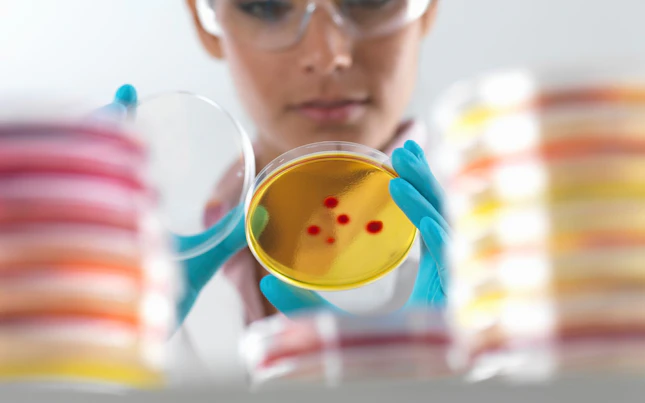
Agricultural Commodities Testing

Soluzioni di test analitici completi per garantire la conformità alle norme di qualità e sicurezza.
Il processo di movimentazione delle materie prime agricole attraverso le varie catene di approvvigionamento può mettere a repentaglio la qualità e la sicurezza delle merci. Un'efficace strategia di test analitici può aiutare a identificare rapidamente i problemi, consentendo al proprietario del carico di prendere decisioni tempestive per ridurre al minimo il rischio e i disagi.
Forniamo una gamma completa di soluzioni di test analitici per i mercati delle materie prime agricole. I nostri esperti del settore utilizzano le più recenti tecnologie e metodologie innovative, fornite attraverso una impareggiabile rete globale di laboratori di analisi all'avanguardia, per garantire che i vostri prodotti agricoli siano conformi alle norme di qualità e sicurezza. Grazie alla nostra competente conoscenza locale e alla nostra esperienza globale, disponiamo delle capacità necessarie per aiutarvi a condurre operazioni commerciali di successo e a basso rischio in mercati globali complessi.
In qualità di analista approvato e membro responsabile della Grain and Feed Trade Association (GAFTA) e della Federation of Oils, Seeds and Fats Association (FOSFA), possiamo ispezionare, verificare, analizzare e fornire consulenza su un'ampia gamma di prodotti agricoli (ad es. cereali, legumi, riso, spezie, mangimi, colza, soia, semi di girasole) commerciati ai sensi dei termini contrattuali GAFTA e FOSFA.
SGS è riconosciuta come punto di riferimento per qualità e integrità. Ovunque operiate nel mondo, siamo pronti ad aiutarvi a scoprire il vero valore dei vostri prodotti agricoli.
Cercate qualcosa di specifico?
Cerca Test delle materie prime agricole
Per chi parla italiano
Zugerstrasse 57,
6340, Baar, Svizzera